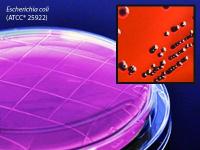

Medium Emb Levine Agr Cont Plt 12ml , Pack Of 10
$ 51.40
|
|
Details:
EMB 12Ml Plate 10Pk^ EMB Levine Agar (Eosin Methylene BlUe), 15x60mm contact plate for sUrface testing, 12ml, order by the package of 10, by Hardy Diagnostics
Additional Information
| SKU | 23355990 |
|---|---|
| UOM | Pack of 10 |
| UNSPSC | 41106204 |
| Manufacturer Part Number | P09 |
| Product Dimensions | 3X3X7 Inches |
| Product Weight | 0.5 |
